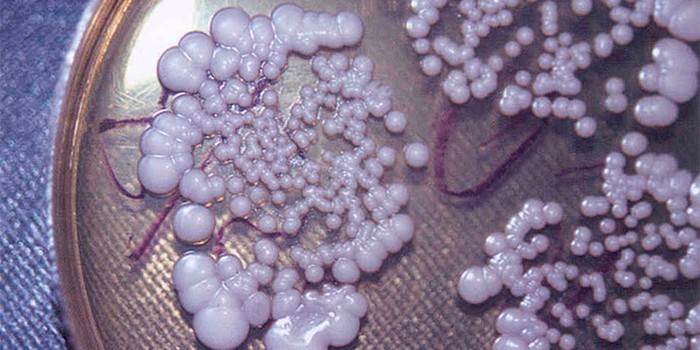
image

Острая кишечная инфекция, вызываемая брюшнотифозной палочкой, именуется брюшным тифом. Заболевание имеет строго циклическое течение с характерными симптомами поражения желудочно-кишечного тракта. Диагностировать патологию помогут лабораторные анализы крови, мочи, кала.
Возбудитель заболевания
Причиной развития инфекции является микроорганизм сальмонелла. Она подвижна, живет и размножается при низких температурах. Для человека опасен вырабатываемый ею эндотоксин. Большое количество тифозной палочки в крови (бактериемия) вызывает увеличение селезенки и печени, нарастающую интоксикацию, поражение лимфотока тонкого кишечника.
Вирулентность сальмонеллы брюшного типа очень высока, но уменьшается под воздействием ряда факторов. Вирус погибает при кипячении, воздействии солнечных лучей, дезинфицирующих средств – этилового спирта, сулемы, хлорамина.
Заражение происходит фекально-оральным и бытовым путями через воду и пищу. Инфекция передается только от человека к человеку, при этом носителем может быть как больной, так и здоровый. Хроническое носительство отмечено в 5% случаев, летальный исход – не более 1%.
Мнение врачей:
Анализ на брюшной тиф является важным методом диагностики данного заболевания, особенно в случаях подозрения на инфекцию у пациентов с соответствующей симптоматикой. Врачи рекомендуют проводить анализ крови на наличие антител к бактерии Salmonella typhi, вызывающей брюшной тиф. Для достоверности результатов необходимо соблюдать все рекомендации по подготовке к анализу, включая соблюдение времени сдачи и диеты. Проведение анализа на брюшной тиф позволяет своевременно выявить заболевание и начать лечение, что существенно снижает риск осложнений и способствует быстрому выздоровлению пациента.

Когда назначается анализ крови на брюшной тиф
Заболевание имеет неспецифичные признаки. Необходимо проводить анализ на брюшной тиф для санкнижки людям, работающим с продуктами, прибывшими из стран с жарким климатом и при наличии первых клинических проявлений. Основные симптомы:
- лихорадка;
- запор или диарея;
- серый налет на языке;
- заторможенность сознания;
- красная сыпь на теле;
- боль, вздутие живота;
- влажный кашель;
- снижение аппетита;
- кровь в кале;
- тошнота, рвота;
- сильная жажда.
Статьи по теме
- Антибиотики пенициллинового ряда – перечень медикаментов с описанием и составом
- Ротавирусная инфекция – симптомы у ребенка или взрослого, их отсутствие и неспецифические проявления
- Препараты при брадикардии – список лекарственных средств с описанием, противопоказаниями и дозировкой
Виды анализов на брюшной тиф
Дифференциальная диагностика патологии состоит из лабораторных методов исследования. Проводить исследование можно в муниципальных больницах или платных лабораториях. Методы исследования:
- Общеклинические – указывают на общее состояние больного, степень дегидратации, присутствие воспалительного процесса. Степень точности исследований низкая.
- Бактериологические – применяются для выявления возбудителя разновидности тифа в организме, имеют среднюю степень точности.
- Серологические – самая точная группа методов определения антигенов брюшной палочки.


Опыт других людей
Анализ на брюшной тиф является важным методом диагностики этого опасного инфекционного заболевания. Люди, которые проходили данный анализ, отмечают его высокую точность и надежность результатов. Обычно этот анализ назначается в случаях подозрения на брюшной тиф, особенно при наличии характерных симптомов: высокая температура, слабость, боли в животе. Проведение анализа на брюшной тиф требует сдачи крови пациентом, после чего специалисты проводят исследование на антитела к возбудителю болезни. Важно соблюдать все рекомендации врача для достоверных результатов и своевременного начала лечения.
Бактериальный посев
Данная группа методов применяется для ранней специфической диагностики болезни. Анализы проводятся до начала использования антибактериальной терапии. Материалом для исследования являются биологические жидкости (моча, кровь, желчь, кал). Краткое описание методов:
|
Название исследования |
Характеристика |
Способ забора биоматериала |
Стоимость, руб |
|
Гемокультура |
Посев крови на питательную среду из желчи, глюкозы и красителя. Исследование проводится на пике повышения температуры. |
Кровь из локтевой вены. Необходимо 2-3 разовое проведение бакпосева. |
450-3400 |
|
Копрокультура |
Копрограмма применяется для установления носительства патологии. Его проводят для сотрудников водоканалов, сети общественного питания школ, садов. |
Исследуется 10-15 г мягкого кала, содержащиеся в нем примеси слизи, крови, гноя. |
510-2300 |
|
Уринокультура |
Для посева мочи используется осадок, который помещают в центрифугу, а затем высевают на питательные среды. |
40-50 мл мочи собирают в стерильный контейнер после проведения гигиены внешних половых органов. |
750-2000 |
Серологические методы исследования
Данные методы применяют не ранее 2-й недели заболевания. Серологическая диагностика основана на выявлении особых антигенов и антител в крови больного. Используются методы ИФА (иммуноферментный анализ), коагглютинация (обнаружение антигенов при помощи антител и электролита). Основные серологические реакции:
|
Наименование |
Описание |
Особенности |
Средняя цена, руб |
|
Реакция непрямой гемагглютинации (РНГА) |
Определение антител и антигенов при помощи эритроцитов, которые выпадают в осадок при наличии иммуноглобулинов. |
Кровь из локтевой вены берется натощак. |
650 |
|
Реакция Видаля |
Поэтапное разведение кровяной сыворотки после ее свертывания. Помогает определить наличие О-антигена. |
15 мл венозной крови из локтя |
900 |
|
РПГА на брюшной тиф (реакция пассивной гемагглютинации) |
Обнаружение специфических антител к возбудителю |
Сдается кровь из локтевой вены |
700 |

Клинический анализ
Применяется при первом обращении больного к врачу. Изменения значений напрямую не диагностируют брюшной тиф, но способствуют установлению общего состояния пациента. К клиническим относятся:
- Общий анализ крови (гемограмма) – проводится на показатели СОЭ (скорости оседания эритроцитов), наличие лейкопении (снижение лейкоцитов) и лейкоцитоза (уменьшение сопротивляемости организма). Средняя стоимость составляет 300 рублей.
- Биохимический – определение концентрации белков, что свидетельствует о стадии болезни. Цена варьируется в пределах 300-500 рублей.
- Общий анализ мочи – установление наличия и увеличения количества эритроцитов и белков. Средняя стоимость – 250 рублей.
Другие методы
Для диагностики болезни используются дополнительные методы. К ним относятся:
- выявление специфических глобулинов М к сальмонеллам тифа (600 руб);
- ПЦР-анализ на установление ДНК возбудителя (350 руб);
- рентгенография грудной клетки (500 руб);
- УЗИ органов брюшной полости (800 руб);
- эхокардиограмма (400 руб).
Как сдается анализ на тифозную палочку
Для достоверности полученных данных следует правильно подготовиться к исследованиям на тиф. Основные правила:
- Сдавать биоматериал утром натощак.
- За сутки до анализа не употреблять алкоголь, жирную пищу.
- Не следует курить за 3-4 часа до проведения исследования.
- В течение 3 дней до анализа следует по возможности исключить применение лекарств.
- Отказаться от усиленных физических и эмоциональных нагрузок.

Расшифровка результатов
Если заключение по анализам отрицательное, то это свидетельствует об отсутствии патологии в 90% случаев. На ранних этапах антитела могут быть не обнаружены, потребуется повторная сдача анализов. В этом случае отрицательный результат говорит о том, что человек переболел тифом. Положительное заключение свидетельствует о наличии острой инфекции или ее носительстве.
Видео
Внимание!
Информация, представленная в статье, носит ознакомительный характер. Материалы статьи не призывают к самостоятельному лечению. Только квалифицированный врач может поставить диагноз и дать рекомендации по лечению, исходя из индивидуальных особенностей конкретного пациента.
Статья обновлена: 21.11.2018
Частые вопросы
Как берут анализ крови на брюшной тиф?
Серологический анализ крови на брюшной тиф назначают для выявления специфических антител к антигенам сальмонеллы. Для анализа берут венозную кровь, из которой в лаборатории готовят сыворотку. Исследование делают методом РПГА — реакция прямой агглютинации.
Сколько стоит сдать анализы на брюшной тиф?
Цена 450 ₽ | Лаборатория Литех
Когда берется кровь на Гемокультуру при брюшном тифе?
Метод гемокультуры можно использовать с первых дней заболевания и до конца лихорадочного периода, желательно до начала лечения. Для этого 5—10 мл крови из локтевой вены больного засевают на 20 % желчный бульон или среду Рапопорта, мясопептонный бульон с 1 % глюкозы, либо даже в стерильную дистиллированную воду.
Как определить брюшной тиф?
исследование мочи, копрограмму, исследование стула, бактериологический посев биологического материала, крови, кала на питательные среды, чтобы культивировать возбудителя, выявить его и определить чувствительность к препаратам, серологические тесты, которые проводятся для оценки уровня антител к антигенам брюшного тифа.
Полезные советы
СОВЕТ №1
Если у вас возникли симптомы, подозрительные на брюшной тиф (высокая температура, слабость, боль в животе), обязательно обратитесь к врачу для профессиональной консультации и диагностики.
СОВЕТ №2
При подозрении на брюшной тиф не занимайтесь самолечением или принятием антибиотиков без рекомендации врача, так как это может привести к осложнениям и ухудшить состояние.
СОВЕТ №3
При проведении анализа на брюшной тиф следуйте всем рекомендациям врача относительно подготовки к исследованию, чтобы результат был максимально точным.
